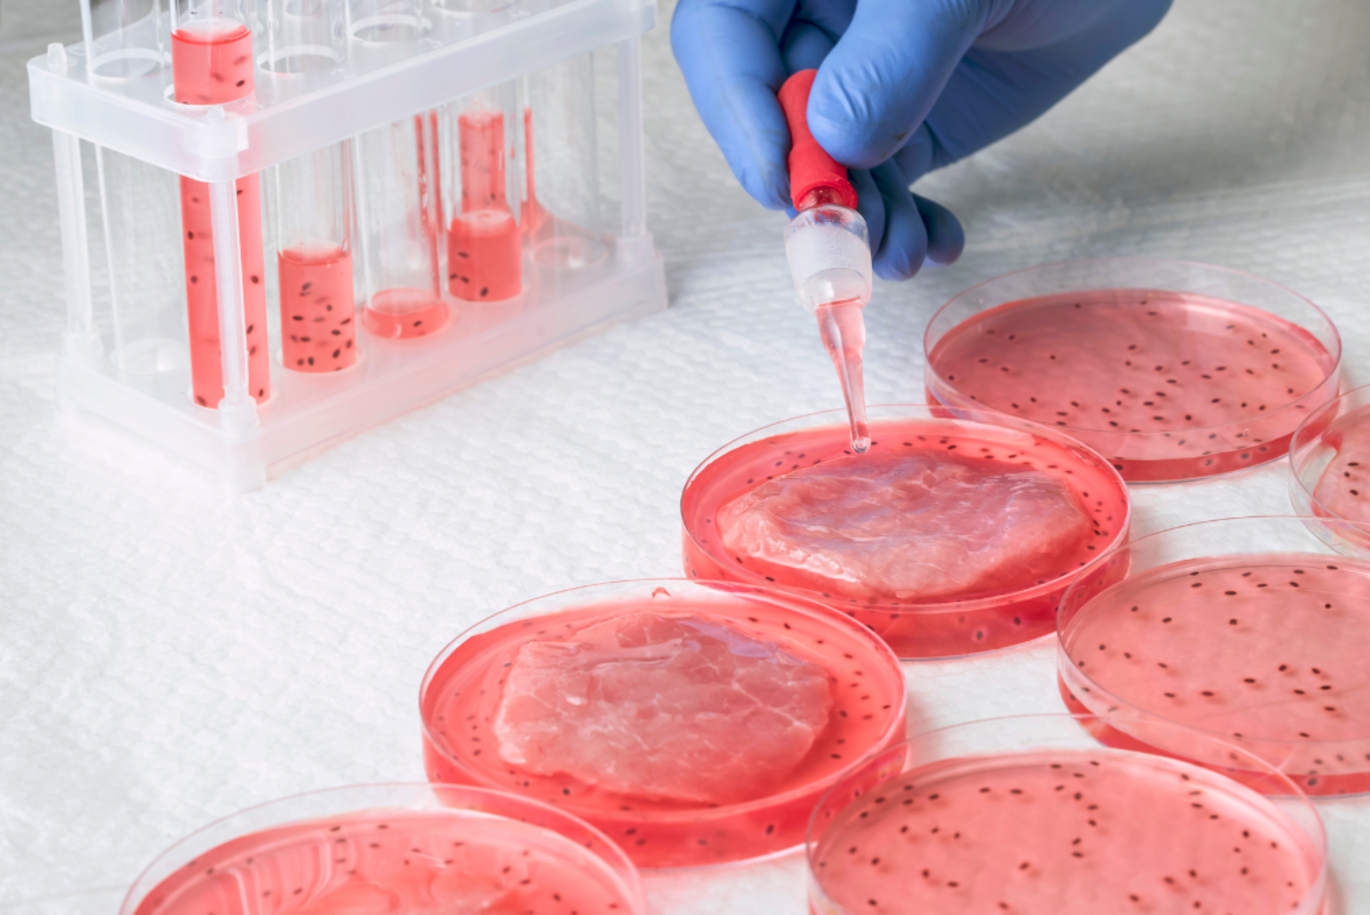

Stay up to date on food innovation: Join AU CellFood Hub community
The CellFood Hub at Aarhus University is launching a new network bringing together stakeholders, scientists, industry, policy makers and people working with or interested in cellular agriculture.
In Singapore you can buy cultivated chicken grown in a bioreactor at the butcher and in the United States, you can buy precision fermented milk alternatives and taste cultivated meat at a few high-end restaurants.
In Europe, the reality of products made with cultivation or precision fermentation is inching closer, as several cultivated products are currently in process of being approved for sale. And other cell-based products, for instance from fungi and microbial based ingredients are already available in many countries.
With these advances, cellular agriculture is no longer a distant vision — it’s becoming a reality.
Aarhus University’s Department of Food Science is leading the way with AU CellFood Hub, a flagship initiative dedicated to advancing research and innovation in cellular food production.
“Cellular agriculture isn’t rocket science, it’s just science, but to a lot of people it still feels new and scary. We have a big responsibility to inform consumers about what is happening in bioreactors and fermentation tanks,” says Jette Feveile Young, professor at Aarhus University’s Department of Food Science and leader of the CellFood Hub.
Right around the corner
With growing global interest in sustainable food systems, cultivated meat, milk alternatives, and precision and biomass fermentation, the demand for knowledge and dialogue is accelerating.
A platform distributing reliable, science-based information on the subject is important to establish now, as the first muscle and lipid cell-based products approach market approval in Europe, and public interest is expected to surge.
“It’s important to create a community that gathers stakeholders, scientists, industry, policy makers and people with a general interest in the field, and that is what AU CellFood Hub is now launching,” Jette Feveile Young says.
What is the AU CellFood Hub?
The AU CellFood Hub is a leading initiative dedicated to research and innovation within cellular agriculture. The hub was formed in 2022.
The hub supports the development of projects ranging from technological solutions to consumer acceptance, generating knowledge on both the development of cellular foods and their way to market.
The CellFood hub aims to bridge these gaps by facilitating the CellFood partnership across research disciplines, by implementing a blended portfolio of activities and by building transparency and trust through public engagement and education.
New community
This new platform aims to foster dialogue and collaboration in one of the most transformative areas of food science.
AU CellFood Hub community will serve as a dynamic platform for knowledge sharing, funding opportunities, and access to news and events within the framework of the AU CellFood Hub.
By joining the community, members will receive newsletters, invitations to events, and opportunities to contribute to discussions about the development and adoption of cellular food technologies.
Sign up for our newsletter and become a part of the community today.
